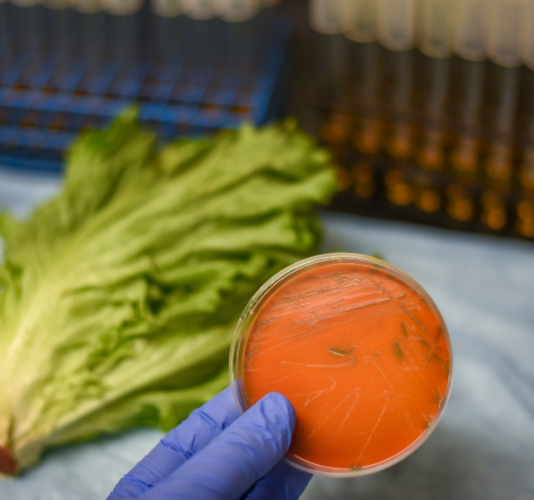
Food Association Germany: Guideline for Listeria Prevention Food Association Germany: Guideline for Listeria Prevention

News
24.03.2025 - Foods
Food Association Germany: Guideline for Listeria Prevention
At the end of 2023, the Food Association Germany published the “Guideline for Good Practice Recommendations for Preventive Measures against Listeria monocytogenes in Certain Areas of Food Production”.
The following is an overview of some important contents of the guideline:
- Preventive measures against listeria in operations
- Categorization of products according to Regulation (EC) 2073/2005
- Challenge tests
- Environmental monitoring for Listeria spp. and/or Listeria monocytogenes
- Raw material and product examinations
- Measures in case of elevated test results
- Legal reporting and notification obligations
On March 25, 2025, we offer you a free BAV online seminar on the topic “EU Regulation 2024/2895 on Listeria – Innovations for Operations” on the topic Listeria monocytogenes. More info can be found here.
Further information on listeria can also be found at the BfR - Federal Institute for Risk Assessment under the following link.
In our Tentamus laboratories, we regularly carry out examinations for Listeria monocytogenes and Listeria spp. We provide you with fast and reliable results.
Our customer advisors are very happy to answer your questions.
Sources:
www.lebensmittelverband.de
www.lebensmittelverband.de
www.bfr.bund.de